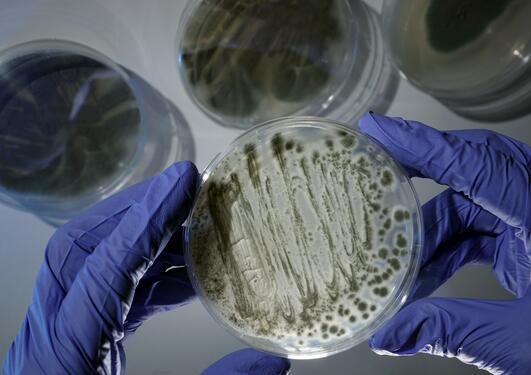

De fleste biologiske prosesser krever energi og er nøye regulert. Mange av disse prosessene involverer molekylet NAD eller NADP. NAD og NADP er små molekyler i kroppen, som blir dannet av Vitamin B3. De som fungerer som midlertidige energibærere og regulerer også vitale cellulære funksjoner.
Vi utforsker de molekylære mekanismene som knytter sammen kroppens energistoffskifte og signaloverføring.
Gruppen er en del av forskningsenheten Systembiologi og Translasjonell Cellesignalering.